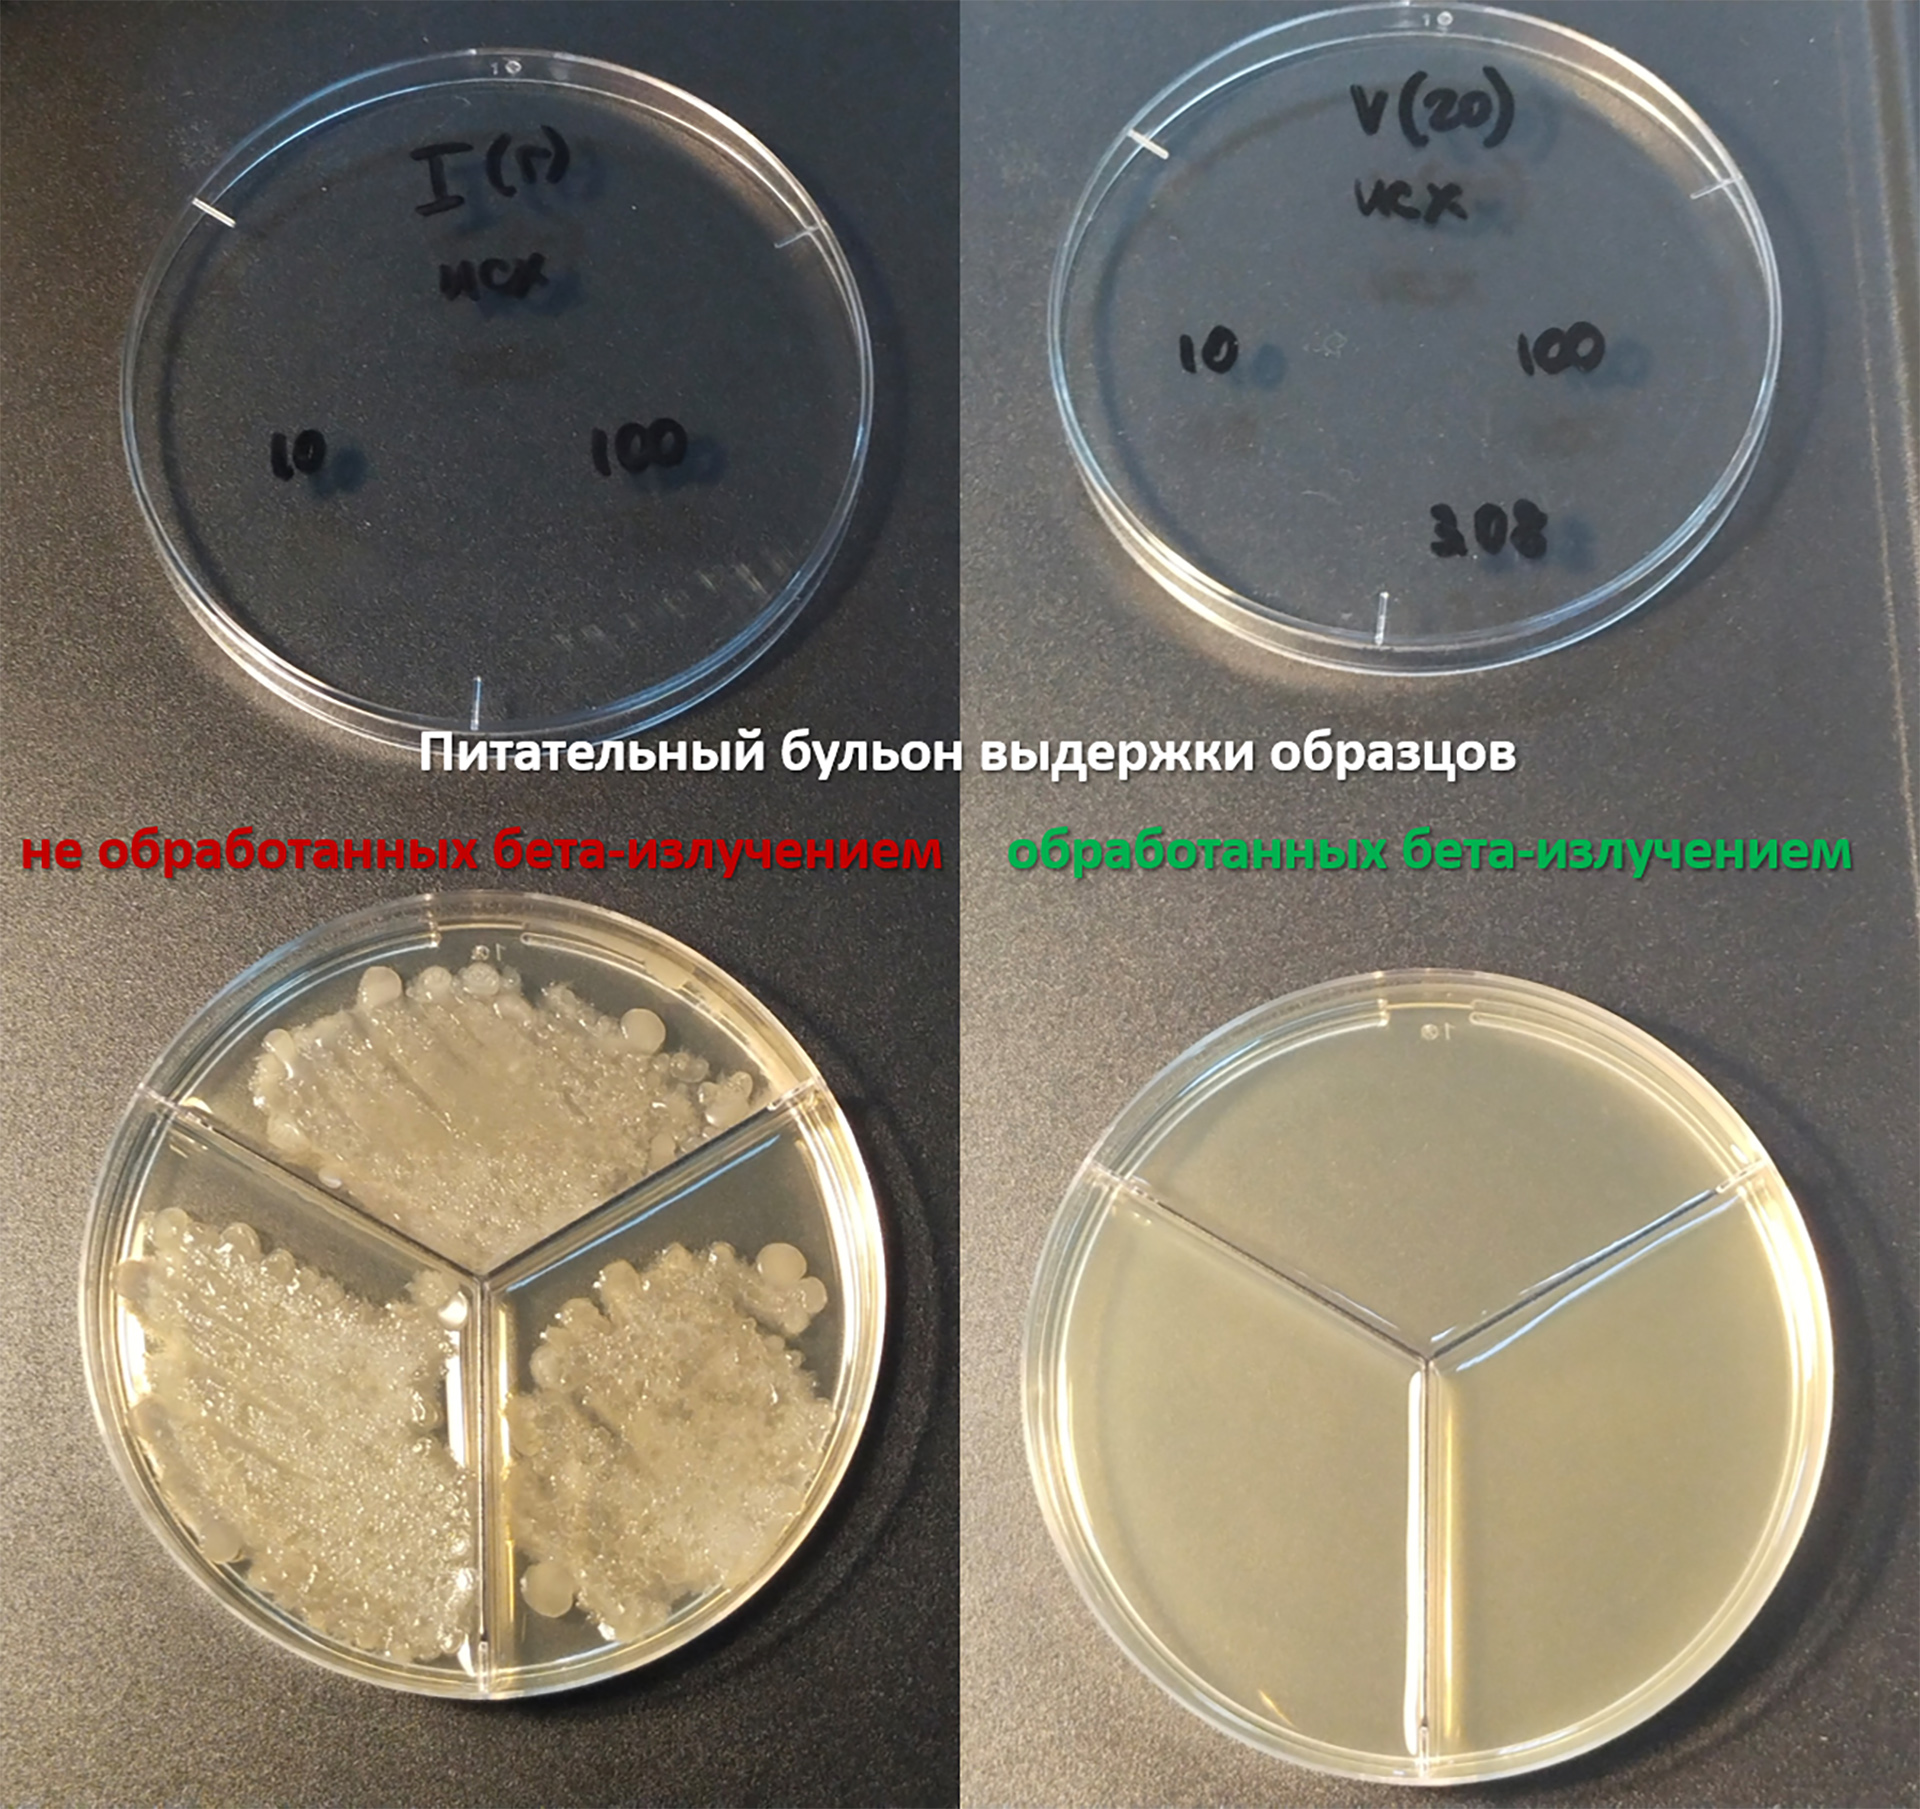
123

Ray to Health: Smart implants can treat tumors and infections
Scientists from Siberia are creating smart implants that can release drugs directly into the patient's body. The researchers also found a way to effectively and safely sterilize implantable structures that contain antibiotics and anticancer drugs using high-energy electrons. This will allow doctors to avoid infections in the patient. The proposed method will bring closer the application of the new technology in clinical practice, experts told Izvestia. This will be especially in demand in orthopedics and maxillofacial surgery, experts say.
What are smart implants?
A group of researchers from the Institute of Strength Physics and Materials Science of the Siberian Branch of the Russian Academy of Sciences, the Institute of Solid State Chemistry and Mechanochemistry of the Siberian Branch of the Russian Academy of Sciences and the Budker Institute of Nuclear Physics of the Siberian Branch of the Russian Academy of Sciences has created a prototype of a smart implant that gradually releases an antibiotic or antitumor drug directly into the focus of the disease — for example, in bone tissue after surgery to remove a bone tumor or during treatment osteomyelitis (inflammation of bones).
To do this, the authors applied a porous coating of calcium phosphate, a bioactive material similar in chemical composition to bone tissue, to the surface of the titanium plate. The antibiotic vancomycin was introduced into the pores of this coating to fight infections, such as staphylococcus aureus, or the antitumor drug fluorouracil. In order for the drug to be released gradually, a biodegradable copolymer consisting of lactic and glycolic acids was applied to the surface of the calcium phosphate coating.
As doctors explained to Izvestia, modern implantable structures accelerate tissue repair and replace damaged organs, and often — for example, when implanting pacemakers — save patients' lives. However, doctors often encounter infections when installing such devices, especially in the case of orthopedic and dental implants. To solve these problems, scientists are developing complex systems — smart implants. They consist of metals and alloys that are coated with organic and inorganic compounds that are biocompatible and safe for the human body. To prevent bacterial infections, antibiotics are applied to the surface of the implants, which should be slowly released in the focus of inflammation. And in pathological cases, for example, in osteooncology — tumors of bones, joints and muscles — an antitumor drug is introduced into the implants, which is also gradually released and thereby prevents the recurrence of cancer.

All medical implants must be sterilized before being inserted into the human body, but in the case of complex multicomponent formulations, this cannot always be done using standard methods. Researchers have proposed an alternative method for sterilizing implantable structures that are sensitive to high temperatures and humidity. The new approach is to process a beam of accelerated electrons (beta radiation). It turned out that the electron beam is a much more gentle sterilization option than temperature treatment under pressure and other traditional methods. The analysis showed that even after the maximum radiation dose, the composition of both drugs enclosed in the porous layer of the implant remained virtually unchanged.
"Our results demonstrate that electron beam sterilization is an effective and safe method of disinfection of complex implants and drug delivery systems. This method does not violate the structure and chemical stability of coatings, guarantees their sterility and preservation of medicinal properties for a long time, which opens the way for their clinical use," Ekaterina Komarova, PhD, researcher at the Laboratory of Physics of Nanostructured Biocomposites at the Institute of Strength Physics and Materials Science of the Siberian Branch of the Russian Academy of Sciences, told Izvestia.
How are structures implanted in the body decontaminated?
The scientists tested the antibacterial properties of the samples. To do this, before irradiation, they were coated with a bacterial-fungal mixture of Staphylococcus aureus and Candida albicans bacteria, which most often cause infections. After that, part of the implants was sterilized with an electron beam, and the other part was not processed (it was used as control samples). All samples were placed in a nutrient medium favorable for the reproduction of microorganisms. The tubes with unirradiated samples became cloudy after a day, indicating the proliferation of bacteria and fungi, while the medium with irradiated samples remained completely transparent. Moreover, even after six months of storage, the sterilized structures retained their sterility and antimicrobial activity.

"In the future, we plan to conduct preclinical tests of the developed smart implants subject to electron beam sterilization on laboratory mice and study the dynamics of bone growth in the ectopic bone formation test, a biomedical test that shows how much the material stimulates bone formation," said Ekaterina Komarova.
The work done is a step towards creating smart implants that release the drug in a dosed manner immediately after installation, reducing the risk of infection and disease recurrence. The key feature is electron beam sterilization. Gamma irradiation and ethylene oxide are now widely used in medicine, but such methods are often destructive for coatings containing medicinal substances, said Albert Rizvanov, head of the Personalized Medicine Center of Excellence at Kazan (Volga Region) Federal University.
— Unlike gamma radiation, beta radiation acts quickly, without heat and moisture, so it treats the polymers and the drug molecules themselves more carefully. The most promising areas of application are orthopedics and maxillofacial surgery (prevention of periprosthetic infections), oncoortopedia (local chemotherapy). Drug-released medical devices already exist, but the proven compatibility of multilayer coatings with beta radiation opens the way to the mass production of new smart implants," the scientist explained.
Traditional methods such as autoclaving often destroy sensitive antibiotics or antitumor drugs, which negates their therapeutic effect, said molecular biologist Arina Kholkina.
—The beta radiation method demonstrates high efficiency and safety for the implant structure, which allows for wide clinical application," she said.
The results of the study, supported by a grant from the Russian Science Foundation (RSF), are published in the journal Surfaces and Interfaces.
Переведено сервисом «Яндекс Переводчик»